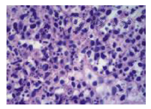

版权归中华医学会所有。
未经授权,不得转载、摘编本刊文章,不得使用本刊的版式设计。
除非特别声明,本刊刊出的所有文章不代表中华医学会和本刊编委会的观点。
组织细胞坏死性淋巴结炎(Kikuchi-Fujimoto disease,KFD)是一种以颈部淋巴结局限肿大、压痛为特征的良性、自限性疾病,病变主要位于颈部。该病常合并淋巴结外表现,起病形式多样,本身具有自限性,且对激素反应敏感,所以在没做淋巴结活检的情况下,容易被误诊。回顾国内报道的相关文献,多数以KFD的病理特征为基础进行描述,以淋巴结外表现为首发症状的报道少,以神经系统损害为首发症状的临床报道更罕见,未见同时有病理资料的报道。青岛大学附属医院神经内科曾收治1例KFD患者,临床以"发热、头痛,发作性意识丧失"起病,腰穿及磁共振检查结果符合无菌性脑膜炎,现将其诊治过程报道如下。
患者女性,23岁,因"发热头痛23 d,发作性意识丧失19 d"于2013年5月1日收治于青岛大学附属医院神经内科。患者2013年4月7日受凉后出现发热、头痛,体温最高达39℃,头痛为全头持续胀痛,无咳嗽咳痰、无恶心呕吐,自服退热药体温降至38 ℃,症状持续4 d。4月11日下午突然出现意识丧失、四肢抽搐,持续约10 min后意识恢复,被送往当地医院行颅脑CT,未见异常,肺部CT检查提示慢性炎症。4月12日行腰穿检查示脑脊液压力高,白细胞数高,糖及氯化物低,蛋白增高,结核杆菌聚合酶链反应检查阳性,具体内容见表1。颅脑MRI增强扫描示脑膜强化(图1),临床拟诊"结核性脑膜炎" ,给予异烟肼、利福平、吡嗪酰胺、链霉素抗结核治疗,丙戊酸钠控制癫痫发作,治疗过程中患者仍有低热头痛,未再出现意识丧失。4月23日复查腰穿白细胞数仍高,糖和氯化物降低,具体内容见表1。4月27日夜间,患者出现高热、大汗,面部及四肢近关节处皮疹、右侧颌下淋巴结肿大、疼痛,予地塞米松静推后体温降至正常,2 h后体温再次升高。于4月28日当地医院行右侧颌下淋巴结活检,患者仍持续发热。5月1日患者转入青岛大学附属医院神经内科。既往史:2010年因发热半月、发作性意识丧失1次,到山东省省立医院就诊,诊断为病毒性脑炎,使用抗病毒、激素治疗,症状好转,但出现双侧股骨头坏死,行双侧股骨头钻孔减压术,遗留有左下肢无力(询问患者,发病时合并有颈部淋巴结肿大,未予处理)。家族史无特殊,无特殊不良嗜好。入院体检:体温38.3 ℃,心率99次/min,呼吸频率18次/min,血压120/60 mmHg(1 mmHg=0.133 kPa)。面部及四肢近关节处多发皮疹。右颌下淋巴结术后改变。心、肺、腹未见异常。神经系统体检:意识清楚,查体合作。左下肢肌力4级,余查体未见阳性体征(脑膜刺激征阴性)。辅助检查:2013年5月2日血常规、血凝常规、尿常规、粪常规、血脂、肝肾功、血糖、电解质、传染性标志物均无明显异常,肺CT示慢性炎症。2013年5月3日及5月7日风湿免疫相关指标检查结果见表2。患者先前的淋巴结活检病理切片送往青岛大学附属医院神经内科复查提示:淋巴结构破坏,无淋巴滤泡淡染,周围见核碎片,组织细胞增生(图2),病理诊断:KFD。结合临床表现和病理结果,最终诊断:KFD。停用抗结核药物,予对症治疗,未使用激素和抗病毒治疗。于5月7日发热头痛消失,皮疹仍存在。5月10日出院。2013年7月4日第1次随访,患者皮疹消失,免疫学检查提示抗核抗体(antinuclear antibody,ANA)阳性。2014年2月8日第2次随访,患者无症状反复,建议继续复查免疫学指标。2014年5月10日第3次随访,患者无症状反复。

患者2次脑脊液检查结果
患者2次脑脊液检查结果
| 项目 | 2013年4月12日 | 2013年4月23日 | 参考值 |
|---|---|---|---|
| 外观 | 无色、透明 | 无色、透明 | - |
| 潘迪氏试验 | 阳性 | 弱阳性 | 阴性 |
| 细胞数 | 300/μL | 40/μL | - |
| 多核细胞/单核细胞 | 80%/20% | 30%/70% | - |
| 葡萄糖(mmol/L) | 2.3 | 2.4 | 2.5~4.5 |
| 氯化物(mmol/L) | 115 | 118 | 120~132 |
| 蛋白(mg/mL) | 1.42 | 0.24 | 0.15~0.45 |
| 结核杆菌脱氧核糖核酸 | 阳性 | 阳性 | 阴性 |
| 柯萨奇病毒抗体免疫球蛋白M | 阴性 | 阴性 | 阴性 |
| EB病毒抗体免疫球蛋白M | 阴性 | 阴性 | 阴性 |
| 单核病毒1型抗体免疫球蛋白M | 阴性 | 阴性 | 阴性 |

患者住院期间及随访时免疫学指标结果对照
患者住院期间及随访时免疫学指标结果对照
| 项目 | 2013年5月3日 | 2013年5月7日 | 2013年5月30日 | 2013年7月4日 |
|---|---|---|---|---|
| 红细胞沉降率(mm/h) | 32.9 | 31.0 | 30.0 | - |
| 抗核抗体 | 阳性 | 阳性 | - | - |
| 抗干燥综合征抗原A抗体 | 阳性 | 阳性 | 阳性 | 阳性 |
| 抗干燥综合征抗原B抗体 | 阳性 | 阴性 | 阴性 | 阴性 |
| 抗Ro-52 kDa自身抗体 | 阳性 | 阳性 | 阳性 | 阳性 |
| 抗双链DNA抗体 | 阴性 | 阴性 | 阴性 | 阴性 |
| 抗Sm抗体 | 阴性 | 阴性 | 阴性 | 阴性 |
| 抗核糖核酸蛋白抗体 | 阴性 | 可疑阳性 | 弱阳性 | 阴性 |
| 补体C(g/L) | - | 1.5 | - | - |
| 补体C4(g/L) | - | 0.124 | - | - |

KFD于1972年由Kikuchi和Fujimoto提出[1,2],故称Kikuchi-Fujimoto disease,又称Kikuchi's disease,histiocytic necrotizing lymphadenitis,中文又称亚急性坏死性淋巴结炎。目前病因尚不明确,多数学者认为KFD发病与病毒感染和病毒感染介导的自身免疫反应有关[3,4,5],有可能是在遗传易感个体中,由多种非特异性刺激引起的T细胞介导的免疫反应[6]。该病特点:亚洲人中多见[6],好发于青年女性。临床上以急性或亚急性起病,病程通常2~3周,也有2~4个月的报道;颈部淋巴结肿大、疼痛,可出现全身淋巴结病变,但极少见;30%~50%患者有发热;少数患者出现体重下降、恶心、呕吐、咽痛、夜间盗汗;50%患者有白细胞减少。该病常合并淋巴结外表现,包括皮肤、眼睛、骨髓损害,消化道症状,肝功异常,神经系统损伤[7]。还有报道KFD与系统性红斑狼疮及其他自身免疫性疾病有关[8,9,10],但相关强度尚不明确。实验室检查无特异性,可出现贫血、白细胞减少、血沉增快。确诊需要淋巴结活检,病理特征为副皮质区凝固性坏死,并有大量的核破裂碎片,坏死周围组织细胞增生,中性粒细胞缺失。
KFD是典型的自限性疾病,病程1~4个月。3%~4%患者可复发,在少数患者中,几年后可发展为系统性红斑狼疮。无家族聚集性。治疗以减轻痛苦为目的,止痛药、退烧药、非甾体类抗炎药用于缓解淋巴结压痛和发热,糖皮质激素可用于严重的淋巴结外病变或全身性KFD[11]。
一项关于244例KFD患者的Meta分析显示,11%的患者合并神经系统损害,包括无菌性脑膜炎、多发性神经炎或急性小脑性共济失调等[12]。多数脑膜炎症状在KFD病程中出现,罕见以脑膜炎症状首发。林华等[13]报道了1例以无菌性脑膜炎为首发症状的KFD患者,可惜未行淋巴结活检。本例患者以头痛、发热起病,2次脑脊液检查示各项指标倾向于结核性脑膜炎的诊断,但患者在未长期进行抗结核治疗的情况下临床症状逐渐好转,并没有出现结核性脑膜炎的其他症状,可以排除结核性脑膜炎的诊断。患者多次化验结果显示抗干燥综合征A抗体阳性,这需与原发性干燥综合征(primary sjogren's syndrome, PSS)相鉴别,但在患者住院及随访期间曾反复询问患者,患者无口干、眼干症状。文献报道PSS的中枢神经系统损害主要以脑实质、脊髓、颅神经受累为主[14],可与本病鉴别。病程中患者出现颈部淋巴结肿痛,行淋巴结活体组织检查显示:淋巴结构破坏,无淋巴滤泡淡染,组织细胞增生,周围见核碎片。在没有继续使用抗结核药物、未使用激素治疗的情况下,患者病情逐渐好转,3个月后症状完全恢复,随访12个月患者无复发,且未再出现新发症状。根据患者病理结果及临床病程,可确诊为KFD。KFD有复发性,回顾本例患者2010年病史,发病与此次发病临床症状相似,患者经抗病毒、激素治疗后好转,不排除2010年为第1次KFD发病,此次发病可能为KFD的第2次发病。有报道KFD患者合并ANA(+)有进展为系统性红斑狼疮的危险[15]。该患者多次免疫学检查提示ANA(+),建议患者继续随诊,定期进行免疫学检查,避免复发或疾病进展。以往病例报道及本病例提示,对于伴有颈部淋巴结肿痛,同时伴有淋巴结外表现的患者应该想到KFD的可能性,尽早行淋巴结活检可及早明确诊断,避免误诊误治和过度治疗。





















